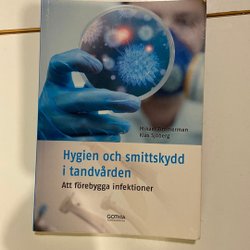

Sluttid18:58 .
Pris:75 kr,Eller Köp nu 130 kr,.
Sluttid18:56 .
Pris:100 kr,Eller Köp nu 125 kr,.
Sluttid18:56 .
Pris:225 kr,Eller Köp nu 250 kr,.
Sluttid18:56 .
Pris:50 kr,Eller Köp nu 65 kr,.
Sluttid18:56 .
Pris:125 kr,Eller Köp nu 150 kr,.
Sluttid17 feb 18:45.
Pris:400 kr,Köp nu.
Sluttid29 jan 18:41.
Pris:33 kr,Utropspris.
Sluttid18:41 .
Pris:300 kr,Eller Köp nu 350 kr,.
Sluttid18:41 .
Pris:200 kr,Eller Köp nu 250 kr,.
Sluttid18:41 .
Pris:50 kr,Eller Köp nu 65 kr,.
Sluttid30 jan 18:35.
Pris:20 kr,Eller Köp nu 40 kr,.
Sluttid1 feb 18:34.
Pris:290 kr,Eller Köp nu 326 kr,.
Sluttid1 feb 18:26.
Pris:150 kr,Utropspris.
Sluttid1 feb 18:21.
Pris:30 kr,Eller Köp nu 50 kr,.
Sluttid18:20 .
Pris:190 kr,Utropspris.
Sluttid1 feb 17:58.
Pris:100 kr,Eller Köp nu 115 kr,.
Sluttid17:50 .
Pris:130 kr,Eller Köp nu 140 kr,.
Sluttid17:47 .
Pris:89 kr,Eller Köp nu 100 kr,.
Sluttid17 feb 17:29.
Pris:90 kr,Köp nu.
Sluttid17 feb 17:29.
Pris:150 kr,Köp nu.
Sluttid17 feb 17:28.
Pris:200 kr,Köp nu.
Sluttid17 feb 17:27.
Pris:200 kr,Köp nu.
Sluttid17 feb 17:27.
Pris:100 kr,Köp nu.
Sluttid17 feb 17:26.
Pris:175 kr,Köp nu.
Sluttid31 jan 17:17.
Pris:100 kr,Eller Köp nu 120 kr,.
Sluttid17:09 .
Pris:100 kr,Utropspris.
Sluttid31 jan 17:07.
Pris:332 kr,Eller Köp nu 347 kr,.
Sluttid31 jan 17:07.
Pris:260 kr,Eller Köp nu 289 kr,.
Sluttid31 jan 17:07.
Pris:173 kr,Eller Köp nu 217 kr,.
Sluttid31 jan 17:06.
Pris:405 kr,Eller Köp nu 434 kr,.
Sluttid17:06 .
Pris:180 kr,Eller Köp nu 225 kr,.
Sluttid17:04 .
Pris:209 kr,Eller Köp nu 219 kr,.
Sluttid17 feb 17:01.
Pris:350 kr,Köp nu.
Sluttid1 feb 16:53.
Pris:30 kr,Eller Köp nu 40 kr,.
Sluttid16:52 .
Pris:180 kr,Eller Köp nu 240 kr,.
Sluttid16:47 .
Pris:180 kr,Eller Köp nu 250 kr,.
Sluttid16:38 .
Pris:90 kr,Utropspris.
Sluttid17 feb 16:38.
Pris:60 kr,Köp nu.